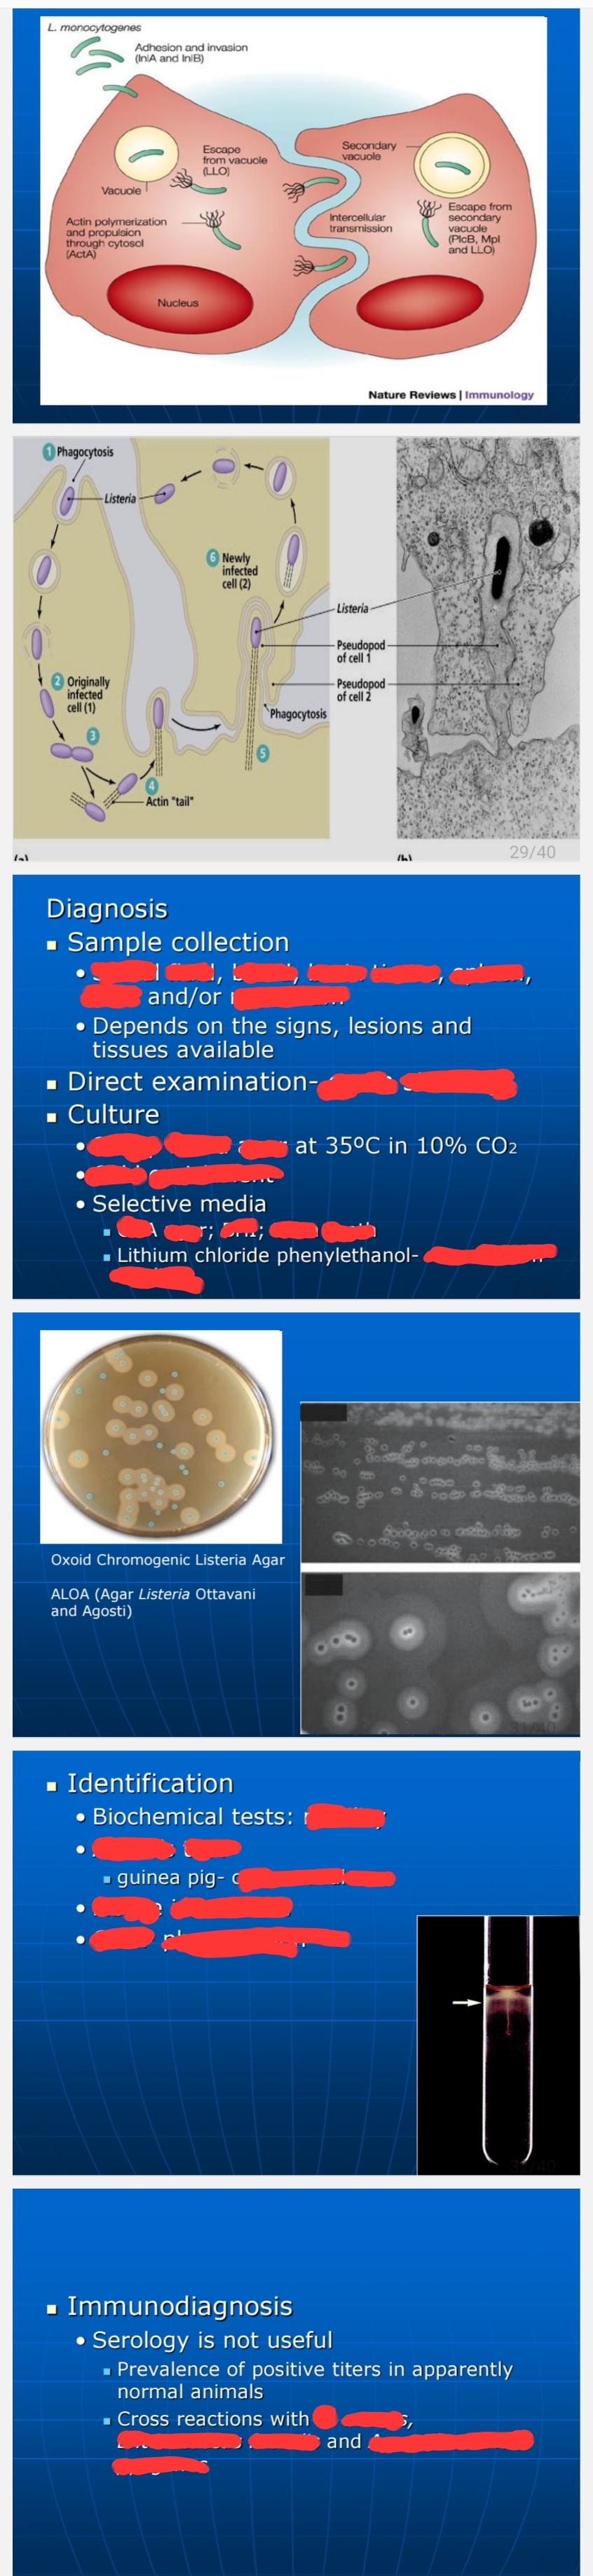

Genus Listeria
1/8
There's no tags or description
Looks like no tags are added yet.
Name | Mastery | Learn | Test | Matching | Spaced |
|---|
No study sessions yet.
9 Terms
“Silage disease”
Epidemiology
● Contaminated silage is the classical source called ?
Septicemia, abortion, meningoencephalitis
Main manifestation of L. monocytogenes: ?, ?, ?
Meningoencephalitis
When an animal with Listeria is opened, there is softening of the brain — medulla oblongata and pons
Circling Disease
● Animal walk in circles
● Affected brain stem — medulla oblongata, pons
● Stress factors predispose to clinical disease
Listeria infection
● Induce an increase in neutrophils
● Release monocytosis producing agent
Common leukogram is monocytosis rather than neutrophilia
Listeria monocytogenes
?
– Surrounded by halo (Oxoid Agar)
– Narrow zone of hemolysis B
Listeria ivanovii
?
– Double, bizonal hemolysis (BAP)
➢ Inner beta, outer alpha hemolysis